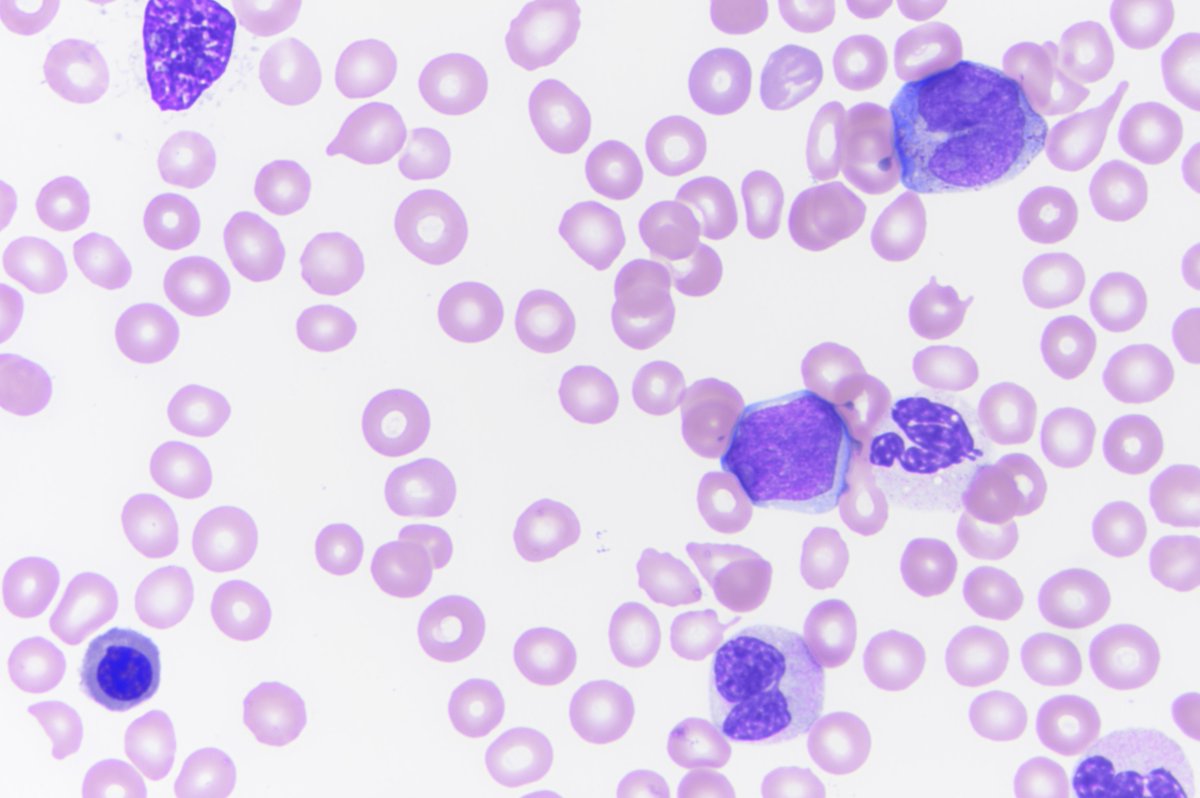
Kristie White, MD tweet media
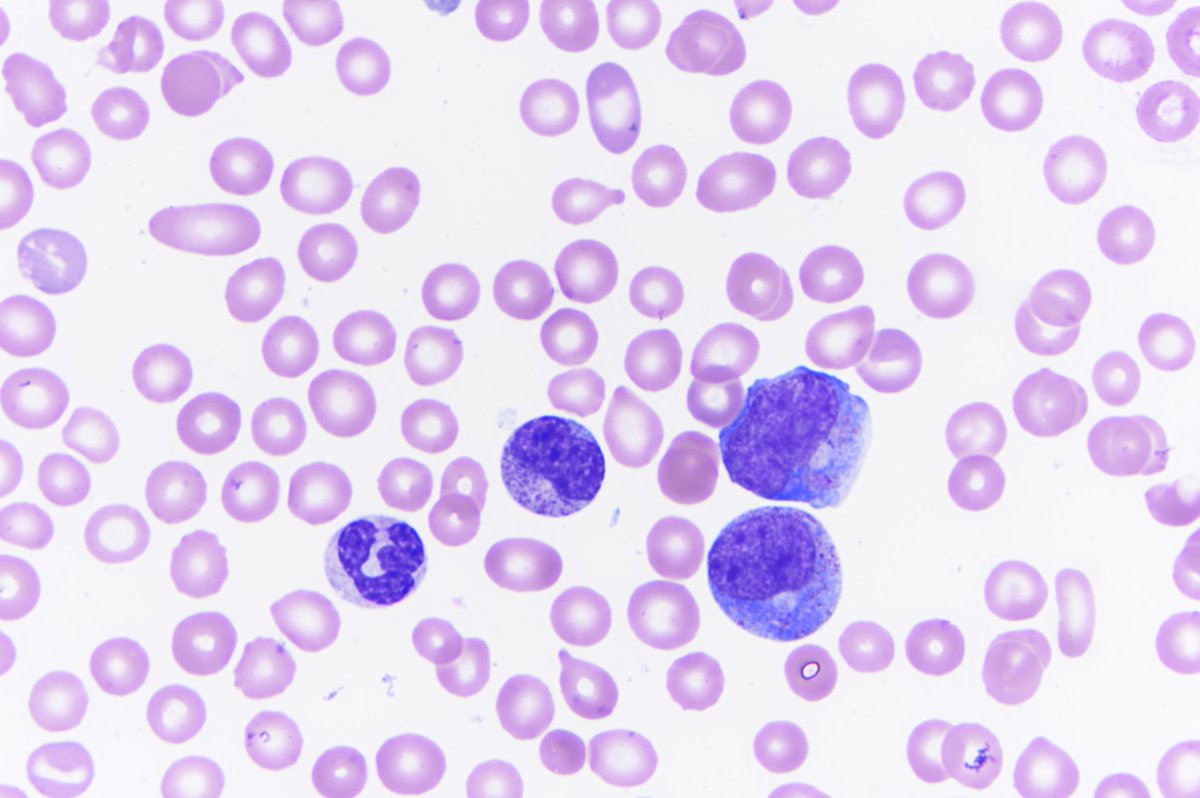
Kristie White, MD tweet media

@SFFFLocal798 @LondonBreed There are 4 blocks that are now dead ends on Capp Street. The barriers have been up a week, and the fire department should be aware. The question to me is “Why so the fire department not aware of a road closure?” These happen all over the city.
English